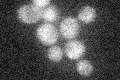
YDL125C
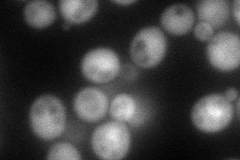
YDL125C
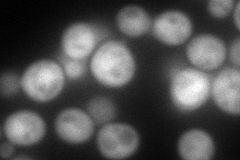
YDL125C
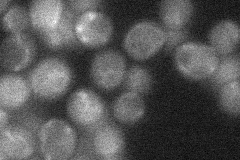
YDL125C
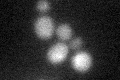
YDL125C
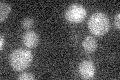
YDL125C

View description
Adenosine 5'-monophosphoramidase; interacts physically and genetically with Kin28p, a CDK and TFIIK subunit, and genetically with CAK1; member of the histidine triad (HIT) superfamily of nucleotide-binding proteins and similar to Hint
Localization:
Intensity:
Fold change:
Significance:
-
C’ GFP library in SD
below threshold17.97 -
N' NOP1pr-GFP in SD
cytosol,nucleus120.694 -
N' TEF2pr-mCherry in SD
cytosol211.93 -
N' NATIVEpr-GFP in SD
below threshold21.1327 -
N' TEF2pr-VC and Cyto-VN in SD

#N/A0 -
C’ GFP library in SD+DTT
cytosol13.470.74No -
C’ GFP library in SD+H2O2

cytosol15.140.84No -
C’ GFP library in Starvation Media
cytosol13.840.77No -
C’ GFP library on the background of Pup2-DaMP

below threshold -
C’ GFP library on the background of CCT mutant

below threshold17.22310.958295No
